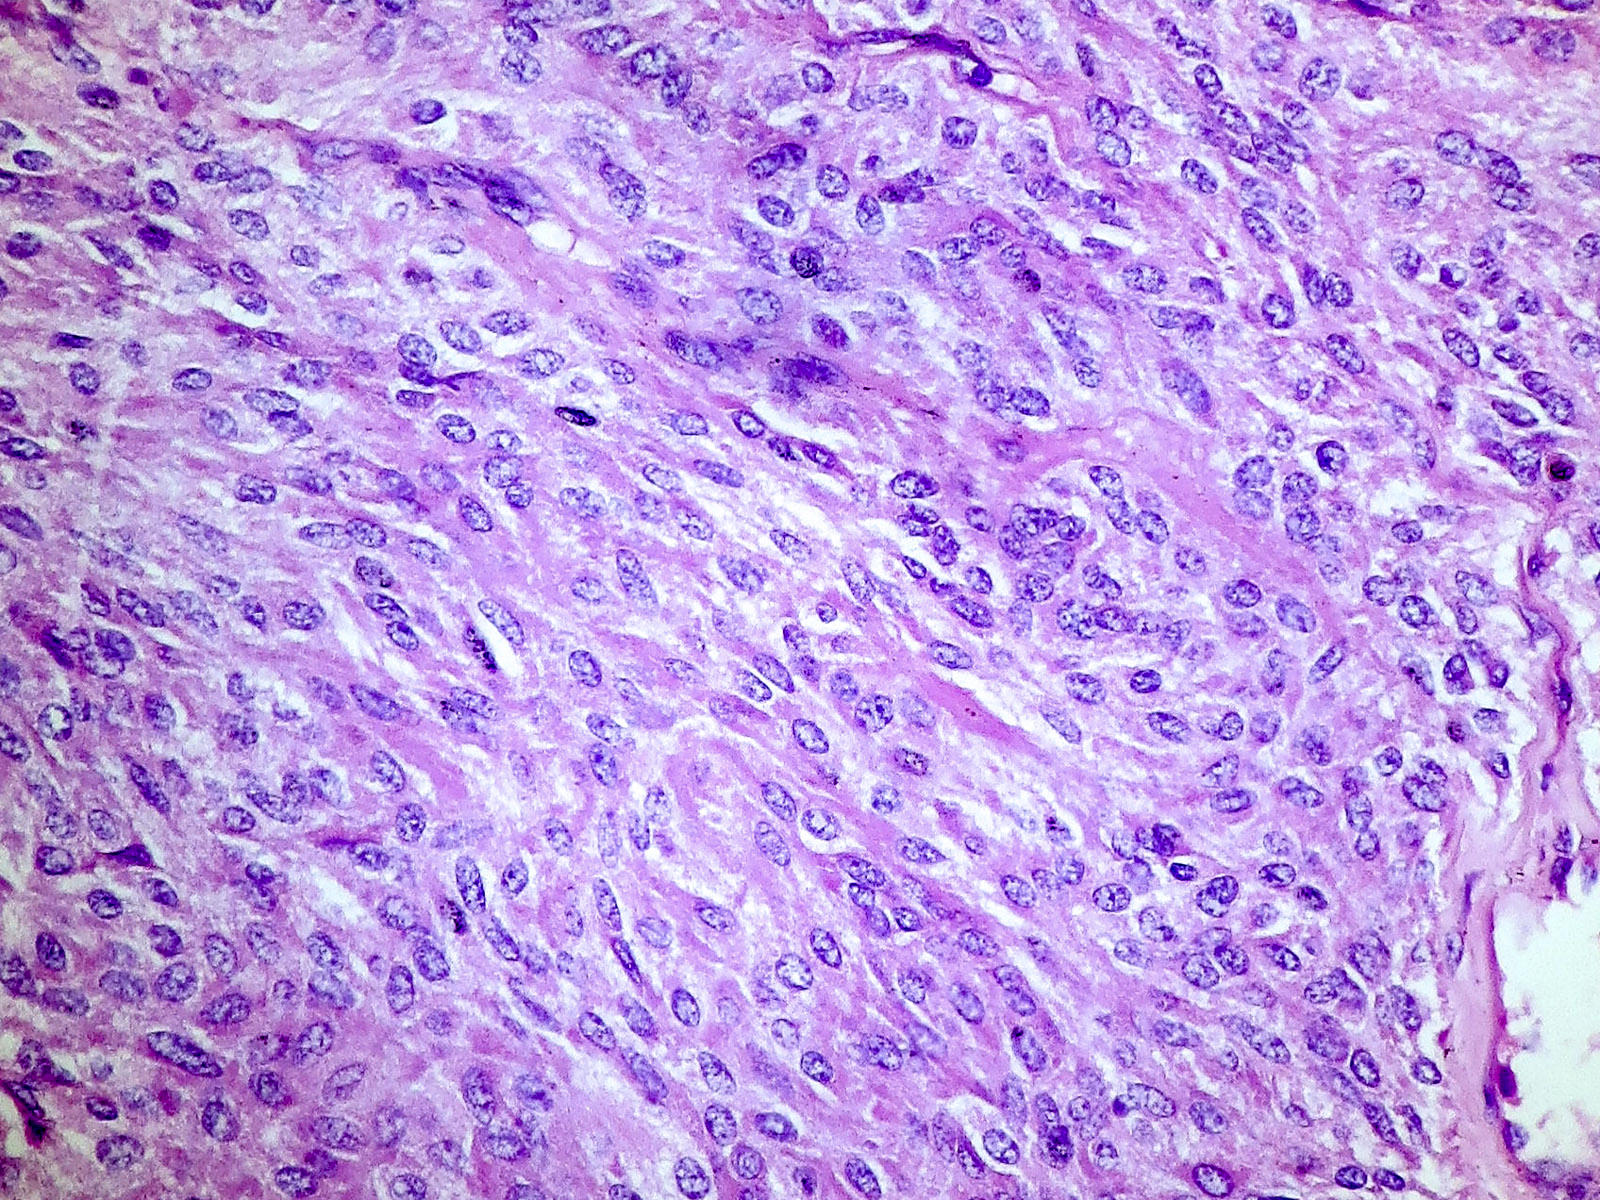

Table of Contents
Definition / general | Essential features | Terminology | ICD coding | Epidemiology | Sites | Etiology | Clinical features | Laboratory | Prognostic factors | Case reports | Treatment | Gross description | Gross images | Microscopic (histologic) description | Microscopic (histologic) images | Cytology description | Cytology images | Positive stains | Negative stains | Electron microscopy description | Electron microscopy images | Molecular / cytogenetics description | Videos | Differential diagnosis | Additional references | Practice question #1 | Practice answer #1Cite this page: Wei S. Medullary thyroid carcinoma. PathologyOutlines.com website. https://www.pathologyoutlines.com/topic/thyroidmedullary.html. Accessed August 18th, 2025.
Definition / general
- Neuroendocrine tumor derived from C cells (formerly called parafollicular cells) of ultimobranchial body of neural crest, which secrete calcitonin
- 1 - 2% of thyroid carcinomas
- Either sporadic (nonhereditary) or familial (hereditary)
- Sporadic: 70%, age 40 - 60, solitary
- Familial: 30%, younger patients (mean age 35)
- Due to MEN 2A or 2B syndromes, familial medullary thyroid carcinoma (FMTC) syndrome, von Hippel-Lindau disease or neurofibromatosis
- Caused by gain of function germline mutations in the RET gene
- Usually bilateral, multicentric with C cell hyperplasia
- Usually discovered by screening test for serum calcitonin or peripheral blood RET oncogene mutational analysis
Essential features
- Thyroid malignant tumor composed of cells with C cell differentiation
Terminology
- Synonyms: C cell carcinoma, solid carcinoma with amyloid stroma, parafollicular cell carcinoma
- Microcarcinoma:
- 1 cm or less
- Often bilateral, rarely lymph node metastases, usually incidental finding
- Common finding in prophylactic thyroidectomies for high risk patients
- Paraganglioma-like variant: rare; may have melanin pigment
- Small cell variant: some small cell carcinomas are variants of medullary carcinoma (Am J Surg Pathol 1980;4:333)
- Tubular (follicular) variant:
- Resembles follicular carcinoma
- Tumor cells form follicular structures lined by cells resembling those in typical or solid portions of tumor
- Lumina are empty or contain colloid type material
Epidemiology
- 1 - 2% of thyroid carcinomas (Thyroid 2015;25:567)
Sites
- Junction of the upper and mid portions of the thyroid lobes
Etiology
- Sporadic: unknown
- Familial: germline mutations in the RET gene
Clinical features
- Presents with painless thyroid mass, cold on scanning
- Up to 75% of patients have nodal metastasis, mostly involving central compartment, ipsilateral and contralateral jugulocarotid chains (Surg Clin North Am 2009;89:1193, J Clin Endocrinol Metab 2003;88:2070); 10% have distant metastasis
- Serum calcitonin correlates with tumor burden (Thyroid 2013;23:294)
- Patients with metastasis may have severe diarrhea and flushing
- Some tumors may produce ACTH or CRH (Cushing syndrome)
Laboratory
- High serum calcitonin and CEA levels
- Can monitor for recurrence with calcitonin and CEA levels
- Only rarely negative for serum calcitonin (World J Surg Oncol 2006;4:97)
Prognostic factors
- 5 year survival: 65 - 90%
- 10 year survival: 45 - 85% (Ann Surg 2007;246:815, Clin Investig 1993;71:7)
- Poor prognostic factors:
- High stage
- Older age, cervical nodal metastases, male, sporadic form, high mitotic activity and vascular invasion (J Clin Endocrinol Metab 2008;93:682, Ann Surg Oncol 2010;17:2444)
- Patients with MEN 2B have a more aggressive clinical course than those with MEN 2A
- Tumor with RET / m918T mutation has been associated with poor clinical outcome (J Clin Endocrinol Metab 2008;93:682, Eur J Endocrinol 2011;164:971, Br J Cancer 2009;100:1777)
- Tumor with RAS mutation may have a less aggressive clinical course (Endocr Relat Cancer 2015;22:R235)
- Favorable prognostic factors: young age, female, familial form, microcarcinoma
- Microcarcinoma: poorer outcome is associated with systemic symptoms, metastatic disease at diagnosis, amyloid (Hum Pathol 1999;30:957), desmoplastic stroma (Am J Surg Pathol 2001;25:1245)
Case reports
- Teenage boy with Cowden syndrome (Laryngoscope 2007;117:1180)
- 22 year old man with occult tumor with nodal metastases (Acta Cytol 2008;52:105)
- 32 year old man with ACTH producing tumor (Hum Pathol 1992;23:592)
- 34 year old woman and 65 year old man with simultaneous occurrence of medullary and papillary thyroid carcinomas (composite tumors, J Med Case Rep 2007;1:133)
- 39 year old woman with undetectable serum calcitonin (J Clin Endocrinol Metab 2015;100:337)
- 42 year old man with ACTH producing tumor (Int Semin Surg Oncol 2007;4:15)
- 45 year old woman with tumor of lingual thyroid (Singapore Med J 2008;49:251)
- 46 year old woman treated with apatinib (Medicine (Baltimore) 2017;96:e8704)
- 48 year old man with metastasizing composite carcinoma with distinct medullary and papillary components (Arch Pathol Lab Med 1994;118:1143)
- 48 year old woman with solitary thyroid nodule and follicular variant (Endocr Pathol 2002;13:75)
- 51 year old woman with Hashimoto thyroiditis (Am J Clin Pathol 1983;80:534)
- 52 year old woman with melanin producing case (Diagn Pathol 2008;3:2)
- 59 year old woman with papillary and medullary carcinoma as separate / collision tumors (Diagn Pathol 2007;2:39)
- 66 year old man presenting with enlarged cervical lymph node and microcarcinoma (Am J Clin Pathol 1986;85:247)
- 66 year old man with thyroid mass (University of Pittsburgh: A Left Thyroid Mass [Accessed 19 March 2018])
- 75 year old man with oncocytic variant of medullary thyroid carcinoma (Rare Tumors 2016;8:6537)
- Encapsulated tumor (Am J Surg Pathol 1991;15:1089)
- Encapsulated tumor resembling hyalinizing trabecular (paraganglioma-like) adenoma (Mod Pathol 1990;3:581)
- Papillary and medullary carcinoma as separate / collision tumors (Am J Surg Pathol 1996;20:245) and as composite tumors (Hum Pathol 1990;21:1151)
Treatment
- Total thyroidectomy (particularly for familial form) with cervical lymphadenectomy for node positive patients
- Microcarcinoma: thyroidectomy, central neck dissection, lateral neck dissection based on serum calcitonin (Surgery 2007;142:1003)
Gross description
- Sporadic: typically presents as a single circumscribed but nonencapsulated, gray-tan mass
- Familial: generally bilateral / multiple foci
- Solid, gray-tan-yellow, firm, may be infiltrative
- Larger lesions have hemorrhage and necrosis, tumor usually in mid or upper portion of gland (with higher density of C cells)
- < 1 cm in size is called microcarcinoma; if < 0.5 cm, associated with a complete absence of clinically detectable metastatic disease (Ann Surg Oncol 2009;16:2875)
Gross images
Contributed by Mark R. Wick, M.D.
AFIP images
Images hosted on other servers:
Microscopic (histologic) description
- Wide variety of morphology, can mimic any other thyroid malignancy
- Round, plasmacytoid, polygonal or spindle cells in nests, cords or follicles; often mixtures of these cells
- Round nuclei with finely stippled to coarsely clumped chromatin and indistinct nucleoli, occasional nuclear pseudoinclusion
- Eosinophilic to amphophilic granular cytoplasm due to secretory granules
- Generally low mitotic figures
- Stroma has amyloid deposits from calcitonin, prominent vascularity with glomeruloid configuration or long cords of vessels (Am J Surg Pathol 1995;19:642), coarse calcifications, occasional psammoma-like bodies
- Mucin in 42% (Arch Pathol Lab Med 1983;107:70)
- Often angiolymphatic invasion
- Occasionally marked neutrophilic infiltrate, oncocytic tumor cells, papillary patterns
- May entrap follicles
- C cell hyperplasia present in familial but not sporadic cases
- Microcarcinoma:
- Complex microarchitectural pattern with desmoplastic stroma, often focal amyloid deposition
- Usually a solid pattern of round, polygonal, spindled or plasmacytoid cells (Arch Pathol Lab Med 2008;132:1767)
- Often C cell hyperplasia (Am J Surg Pathol 2000;24:853)
Variants (important for differential diagnosis, most are of no prognostic importance):
- Amphicrine variant: tumor cells contain mucin and express calcitonin (Ultrastruct Pathol 1985;8:197)
- Angiosarcoma-like variant: cleft spaces with hemorrhage (Diagn Cytopathol 2007;35:424)
- Clear cell variant (Hum Pathol 1985;16:844)
- Encapsulated variant (J Pathol 1971;103:1)
- Follicular variant: has follicles containing eosinophilic secretion (Histopathology 1983;7:83)
- Giant cell variant: large cells with bizarre nuclei, may be more aggressive (Arch Pathol Lab Med 1978;102:445)
- Melanotic variant: with melanin pigmentation (Histopathology 1990;16:227)
- Oncocytic variant: mimics Hürthle cell adenoma / carcinoma but has prominent fibrovascular septa (Cancer 1989;63:1183)
- Papillary variant (Pathol Res Pract 1988;184:98)
- Paragangioma-like variant:
- Nested tumor cells, mimics paraganglioma (Mod Pathol 1990;3:581)
- Nest-like pattern with pigmented dendritic cells resembling sustentacular cells (Arch Pathol Lab Med 1994;118:1041)
- Pseudopapillary variant (Diagn Cytopathol 2014;42:823)
- Small cell variant: similar to small cell carcinoma of lung, highly aggressive (Semin Diagn Pathol 1985;2:137)
- Spindle cell variant: exclusively spindle cells (Adv Anat Pathol 2014;21:26)
- Squamous variant: may have focal squamous differentiation (Cancer 1989;63:1183)
Microscopic (histologic) images
Contributed by Shuanzeng Wei, M.D., Ph.D., Joseph Christopher Castillo, M.D. and Mark R. Wick, M.D.
AFIP images
Images hosted on other servers:
Cytology description
- Cellular specimen with round, ovoid, plasmacytoid or spindle cells singly or in small cluster; cells have abundant cytoplasm and eccentric nuclei; chromatin has salt and pepper appearance
- May have pink azurophilic granules and intranuclear pseudoinclusions; amyloid present occasionally (Am J Clin Pathol 1984;82:552)
- Paraganglioma-like variant:
- Predominantly ovoid to spindled epithelial cells in cohesive three dimensional clusters with sharp margins, rare isolated individual cells, no background colloid or amyloid
- Tumor cells have inconspicuous cytoplasm, significant nuclear atypia with occasional bizarre or binucleated cells, coarse and granular nuclear chromatin with occasional grooves and intranuclear inclusions (Cytopathology 2009;20:188)
Cytology images
Contributed by Ayana Suzuki, C.T. and Shuanzeng Wei, M.D., Ph.D.
Positive stains
- Calcitonin, CEA, TTF1 (weak to moderate), PAX8 (variable and weak) (Mod Pathol 2008;21:192), Congo red for amyloid
- Calcitonin gene related peptide, ACTH, somatostatin, gastrin releasing peptide, neurotension, low molecular weight keratin, chromogranin A and B, synaptophysin, neuron specific enolase, progesterone receptors (Mod Pathol 1996;9:68)
- Immunocytochemistry for calcitonin, CEA and thyroglobulin is useful with thin layer cytology (Appl Immunohistochem Mol Morphol 2008;16:548)
- Paraganglioma-like variant: Fontana-Masson (melanin), calcitonin, S100 (Pathol Res Pract 2000;196:55)
- Small cell variant: calcitonin (usually)
- Tubular (follicular) variant:
- Calcitonin, calcitonin gene related peptide
- Luminal material shows variable staining for calcitonin
Negative stains
- Thyroglobulin (entrapped thyroid follicle can be positive), estrogen receptor
- Paraganglioma-like variant: HMB45 (Arch Pathol Lab Med 1998;122:555)
- Tubular (follicular) variant: thyroglobulin
Electron microscopy description
- Single membrane bound electron dense granules in cytoplasm
- 130 nm and 280 nm secretory granules contain calcitonin
- Tubular (follicular) variant: secretory granules, apical microvilli, well developed desmosomes near luminal poles
Electron microscopy images
Molecular / cytogenetics description
- Gain of function muations in RET proto-oncogene: in majority of hereditary medullary thyroid carcinoma (MTC), 50% in sporadic MTC
- Exon 16 / M918T is the most common mutation
- HRAS and KRAS mutation in RET negative MTC
- MYH13-RET fusion in rare RET / RAS negative MTC
- Other fusion: GFPT1-ALK and EML4-ALK
Videos
Medullary thyroid carcinoma FNA
Medullary thyroid carcinoma
Differential diagnosis
- Hürthle cell carcinoma: eosinophilic not amphophilic cytoplasm, no fibrous bands dividing cells into nests
- Metastatic neuroendocrine carcinoma: primary often discovered only on followup; primarily interstitial spread, multiple tumor foci, folliculotropism and rosettes, negative for calcitonin, focal / negative for CEA (Am J Surg Pathol 1997;21:754)
- Poorly differentiated thyroid carcinoma: thyroglobulin positive, calcitonin negative, no amyloid
- Can mimic various tumors (see variants in Microscopic description): calcitonin and CEA are essential in difficult cases
- Paraganglioma-like variant mimics paraganglioma: negative for calcitonin and thyroglobulin, positive for S100 in sustentacular cells (Am J Surg Pathol 1980;4:589)
Additional references
Practice question #1
Which statement is not true for medullary thyroid carcinoma (MTC)?
- Majority of MTC have translocation involving RET proto-oncogene
- MTC can be monitored for recurrence with serum CEA levels
- MTC has a wide variety of morphology, can mimic any other thyroid malignancies
- MTC is most commonly found at the junction of the upper and mid portions of the thyroid lobes
- MTC is positive for TTF1, synaptophysin and chromogranin
Practice answer #1
A. Majority of medullary thyroid carcinoma (MTC) have translocation involving RET proto-oncogene is false. The majority of MTC have gain of function mutations in RET gene. MYH13-RET fusion can be found in rare RET / RAS negative MTC. RET-PTC rearrangement is found in papillary thyroid carcinoma.
Comment Here
Reference: Medullary
Comment Here
Reference: Medullary